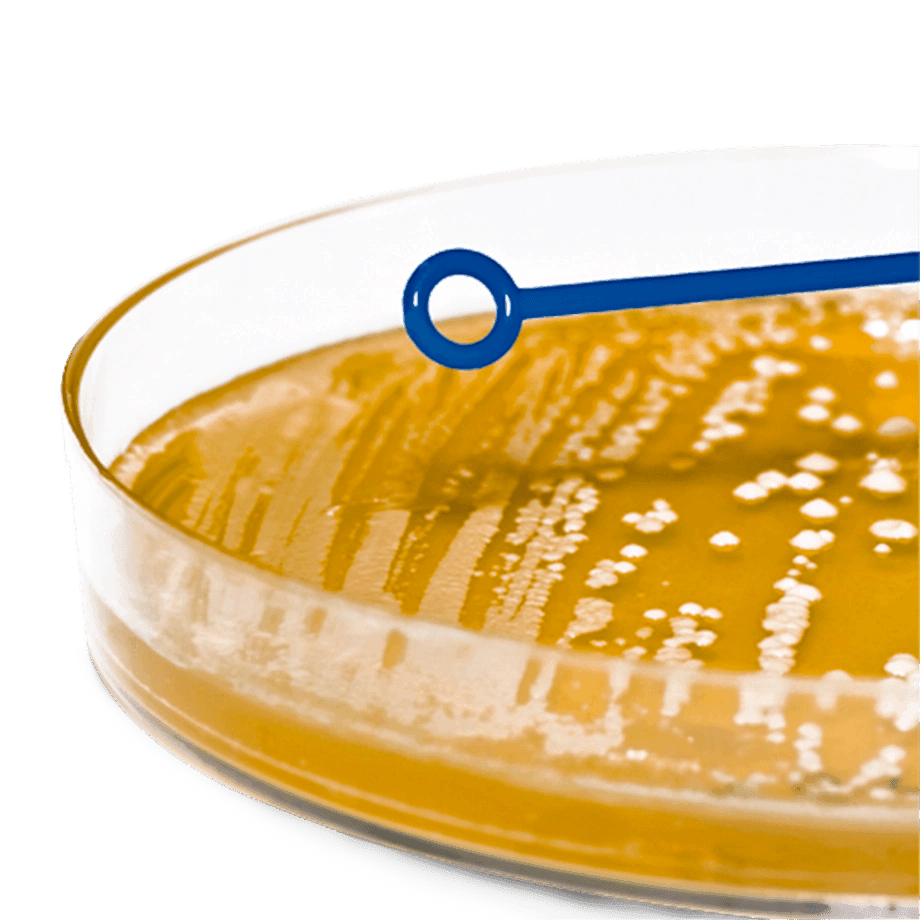

Filtros
Ordenar Más vendidos
-
ASAS BACTERIOLÓGICAS DESECHABLES HEATHROW SCIENTIFIC 81121 ESTÉRILES Y DE POLIPROPILENO CON AGUJA ASAS BACTERIOLÓGICAS DESECHABLES HEATHROW SCIENTIFIC 81121 ESTÉRILES Y DE POLIPROPILENO CON AGUJA
$ 47.75 MXNASAS BACTERIOLÓGICAS DESECHABLES HEATHROW SCIENTIFIC 81121 ESTÉRILES Y DE POLIPROPILENO CON AGUJA
$ 47.75 MXNImpuestos incluidos. -
ASA BACTERIOLÓGICA DOBLE 1 UL Y 10 UL DE PLÁSTICO ESTÉRIL ESLAB ASA BACTERIOLÓGICA DOBLE 1 UL Y 10 UL DE PLÁSTICO ESTÉRIL ESLAB
Precio habitual $ 35.15 MXN Precio de oferta $ 33.39 MXNASA BACTERIOLÓGICA DOBLE 1 UL Y 10 UL DE PLÁSTICO ESTÉRIL ESLAB
Precio de oferta $ 33.39 MXN Precio habitual $ 35.15 MXNImpuestos incluidos. -
MICROTUBOS PARA CENTRÍFUGA DE 2.0 ML HEATHROW SCIENTIFIC CON TAPA DE ROSCA MICROTUBOS PARA CENTRÍFUGA DE 2.0 ML HEATHROW SCIENTIFIC CON TAPA DE ROSCA
$ 2,843.06 MXNMICROTUBOS PARA CENTRÍFUGA DE 2.0 ML HEATHROW SCIENTIFIC CON TAPA DE ROSCA
$ 2,843.06 MXNImpuestos incluidos. -
PIPETAS DE TRANSFERENCIA DE PLÁSTICO TIPO PASTEUR ESTÉRILES POR PAQUETE PIPETAS DE TRANSFERENCIA DE PLÁSTICO TIPO PASTEUR ESTÉRILES POR PAQUETE
$ 1,238.22 MXNPIPETAS DE TRANSFERENCIA DE PLÁSTICO TIPO PASTEUR ESTÉRILES POR PAQUETE
$ 1,238.22 MXNImpuestos incluidos. -
BOLSAS ESTÉRILES ESTÁNDAR ROTULABLE NASCO WHIRL-PAK PARA FÁCIL Y RÁPIDA IDENTIFICACIÓN DE MUESTRAS PAQUETE 500 PIEZAS BOLSAS ESTÉRILES ESTÁNDAR ROTULABLE NASCO WHIRL-PAK PARA FÁCIL Y RÁPIDA IDENTIFICACIÓN DE MUESTRAS PAQUETE 500 PIEZAS
$ 2,453.24 MXNBOLSAS ESTÉRILES ESTÁNDAR ROTULABLE NASCO WHIRL-PAK PARA FÁCIL Y RÁPIDA IDENTIFICACIÓN DE MUESTRAS PAQUETE 500 PIEZAS
$ 2,453.24 MXNImpuestos incluidos. -
PAPEL FILTRO WHATMAN CYTIVA 1440 GRADO 40 CUANTITATIVO DE CELULOSA PAPEL FILTRO WHATMAN CYTIVA 1440 GRADO 40 CUANTITATIVO DE CELULOSA
$ 1,639.92 MXNPAPEL FILTRO WHATMAN CYTIVA 1440 GRADO 40 CUANTITATIVO DE CELULOSA
$ 1,639.92 MXNImpuestos incluidos. -
PAPEL FILTRO FIBRA DE VIDRIO AHLSTROM 1110 GRADO 111 SIN AGLUTINANTE PAPEL FILTRO FIBRA DE VIDRIO AHLSTROM 1110 GRADO 111 SIN AGLUTINANTE
$ 2,639.65 MXNPAPEL FILTRO FIBRA DE VIDRIO AHLSTROM 1110 GRADO 111 SIN AGLUTINANTE
$ 2,639.65 MXNImpuestos incluidos. -
CARTUCHO DE EXTRACCIÓN SOXHLET PARA ALTO RENDIMIENTO DE CELULOSA PAQUETE CON 25 PIEZAS CYTIVA CARTUCHO DE EXTRACCIÓN SOXHLET PARA ALTO RENDIMIENTO DE CELULOSA PAQUETE CON 25 PIEZAS CYTIVA
$ 4,115.38 MXNCARTUCHO DE EXTRACCIÓN SOXHLET PARA ALTO RENDIMIENTO DE CELULOSA PAQUETE CON 25 PIEZAS CYTIVA
$ 4,115.38 MXNImpuestos incluidos. -
ELECTRODO DE PH DE PLÁSTICO OHAUS SERIE STARTER ST320 3 EN 1 NO RELLENABLE - GEL 83033967 ELECTRODO DE PH DE PLÁSTICO OHAUS SERIE STARTER ST320 3 EN 1 NO RELLENABLE - GEL 83033967
$ 7,062.21 MXNELECTRODO DE PH DE PLÁSTICO OHAUS SERIE STARTER ST320 3 EN 1 NO RELLENABLE - GEL 83033967
$ 7,062.21 MXNImpuestos incluidos. -
CAJA PARA TRANSPORTE DE MUESTRAS HEATHROW SCIENTIFIC 120052 DURAPORTER DE POLICARBONATO CON CIERRE HERMÉTICO CAJA PARA TRANSPORTE DE MUESTRAS HEATHROW SCIENTIFIC 120052 DURAPORTER DE POLICARBONATO CON CIERRE HERMÉTICO
$ 3,771.90 MXNCAJA PARA TRANSPORTE DE MUESTRAS HEATHROW SCIENTIFIC 120052 DURAPORTER DE POLICARBONATO CON CIERRE HERMÉTICO
$ 3,771.90 MXNImpuestos incluidos. -
TIRAS DE PH PARA CALIDAD DE AGUA 5 EN 1 AQUACHEK HACH 2755250 TIRAS DE PH PARA CALIDAD DE AGUA 5 EN 1 AQUACHEK HACH 2755250
$ 1,331.27 MXNTIRAS DE PH PARA CALIDAD DE AGUA 5 EN 1 AQUACHEK HACH 2755250
$ 1,331.27 MXNImpuestos incluidos. -
TIRAS DE PH 0.0-6.0 PH-FIX MACHEREY-NAGEL 100 PIEZAS TIRAS DE PH 0.0-6.0 PH-FIX MACHEREY-NAGEL 100 PIEZAS
Precio habitual $ 1,033.56 MXN Precio de oferta $ 240.61 MXNTIRAS DE PH 0.0-6.0 PH-FIX MACHEREY-NAGEL 100 PIEZAS
Precio de oferta $ 240.61 MXN Precio habitual $ 1,033.56 MXNImpuestos incluidos. -
PLATILLOS DE PESAJE DE ALUMINIO DE 25 MM HEATHROW SCIENTIFIC 120627 SMARTPAN IDEAL PARA MICRO BALANZAS PAQUETE 20 PIEZAS PLATILLOS DE PESAJE DE ALUMINIO DE 25 MM HEATHROW SCIENTIFIC 120627 SMARTPAN IDEAL PARA MICRO BALANZAS PAQUETE 20 PIEZAS
$ 3,714.66 MXNPLATILLOS DE PESAJE DE ALUMINIO DE 25 MM HEATHROW SCIENTIFIC 120627 SMARTPAN IDEAL PARA MICRO BALANZAS PAQUETE 20 PIEZAS
$ 3,714.66 MXNImpuestos incluidos. -
PAPEL FILTRO FIBRA DE VIDRIO AHLSTROM 1610 GRADO 161 SIN AGLUTINANTE PAPEL FILTRO FIBRA DE VIDRIO AHLSTROM 1610 GRADO 161 SIN AGLUTINANTE
$ 893.77 MXNPAPEL FILTRO FIBRA DE VIDRIO AHLSTROM 1610 GRADO 161 SIN AGLUTINANTE
$ 893.77 MXNImpuestos incluidos. -
FILTRO DE MEMBRANA DE MCE ESTÉRIL CUADRÍCULA NEGRA DE 47 MM CON PORO DE 0.45 UM PAQUETE 100 PIEZAS FILTRO DE MEMBRANA DE MCE ESTÉRIL CUADRÍCULA NEGRA DE 47 MM CON PORO DE 0.45 UM PAQUETE 100 PIEZAS
$ 2,439.17 MXNFILTRO DE MEMBRANA DE MCE ESTÉRIL CUADRÍCULA NEGRA DE 47 MM CON PORO DE 0.45 UM PAQUETE 100 PIEZAS
$ 2,439.17 MXNImpuestos incluidos. -
PAPEL FILTRO CARTUCHO DE EXTRACCIÓN AHLSTROM 7100 PAPEL FILTRO CARTUCHO DE EXTRACCIÓN AHLSTROM 7100
$ 4,186.51 MXNPAPEL FILTRO CARTUCHO DE EXTRACCIÓN AHLSTROM 7100
$ 4,186.51 MXNImpuestos incluidos. -
PAPEL FILTRO AHLSTROM 6310 GRADO 631 CUALITATIVO DE CELULOSA PAPEL FILTRO AHLSTROM 6310 GRADO 631 CUALITATIVO DE CELULOSA
$ 300.36 MXNPAPEL FILTRO AHLSTROM 6310 GRADO 631 CUALITATIVO DE CELULOSA
$ 300.36 MXNImpuestos incluidos. -
PAPEL FILTRO AHLSTROM 6100 GRADO 610 CUALITATIVO DE CELULOSA PAPEL FILTRO AHLSTROM 6100 GRADO 610 CUALITATIVO DE CELULOSA
$ 407.79 MXNPAPEL FILTRO AHLSTROM 6100 GRADO 610 CUALITATIVO DE CELULOSA
$ 407.79 MXNImpuestos incluidos. -
GUANTES PARA ACEITE EN MANTENIMIENTO INDUSTRIAL POR PAR ULTRANE 526 MAPA GUANTES PARA ACEITE EN MANTENIMIENTO INDUSTRIAL POR PAR ULTRANE 526 MAPA
Precio habitual $ 154.69 MXN Precio de oferta $ 86.15 MXNGUANTES PARA ACEITE EN MANTENIMIENTO INDUSTRIAL POR PAR ULTRANE 526 MAPA
Precio de oferta $ 86.15 MXN Precio habitual $ 154.69 MXNImpuestos incluidos. -
ELECTRODO DE PH DE VIDRIO OHAUS SERIE STARTER ST350 3 EN 1 RELLENABLE 30129354 ELECTRODO DE PH DE VIDRIO OHAUS SERIE STARTER ST350 3 EN 1 RELLENABLE 30129354
$ 8,634.89 MXNELECTRODO DE PH DE VIDRIO OHAUS SERIE STARTER ST350 3 EN 1 RELLENABLE 30129354
$ 8,634.89 MXNImpuestos incluidos. -
CELDAS PARA ESPECTROFOTÓMETRO DE VIDRIO CUADRADA DE 3.5 ML UNICO S-90-304-1G CELDAS PARA ESPECTROFOTÓMETRO DE VIDRIO CUADRADA DE 3.5 ML UNICO S-90-304-1G
$ 1,069.65 MXNCELDAS PARA ESPECTROFOTÓMETRO DE VIDRIO CUADRADA DE 3.5 ML UNICO S-90-304-1G
$ 1,069.65 MXNImpuestos incluidos. -
BOLSAS ESTÉRILES DE PIE CON FONDO PLANO NASCO WHIRL-PAK SELF-STAND PARA MUESTREO EN GENERAL BOLSAS ESTÉRILES DE PIE CON FONDO PLANO NASCO WHIRL-PAK SELF-STAND PARA MUESTREO EN GENERAL
$ 3,947.83 MXNBOLSAS ESTÉRILES DE PIE CON FONDO PLANO NASCO WHIRL-PAK SELF-STAND PARA MUESTREO EN GENERAL
$ 3,947.83 MXNImpuestos incluidos. -
BOLSAS ESTÉRILES CON ESPONJA NASCO WHIRL-PAK B01245WA SPECI-SPONGE DE 532 ML (18 OZ) PARA MUESTREO DE SUPERFICIES BOLSAS ESTÉRILES CON ESPONJA NASCO WHIRL-PAK B01245WA SPECI-SPONGE DE 532 ML (18 OZ) PARA MUESTREO DE SUPERFICIES
$ 4,778.55 MXNBOLSAS ESTÉRILES CON ESPONJA NASCO WHIRL-PAK B01245WA SPECI-SPONGE DE 532 ML (18 OZ) PARA MUESTREO DE SUPERFICIES
$ 4,778.55 MXNImpuestos incluidos.